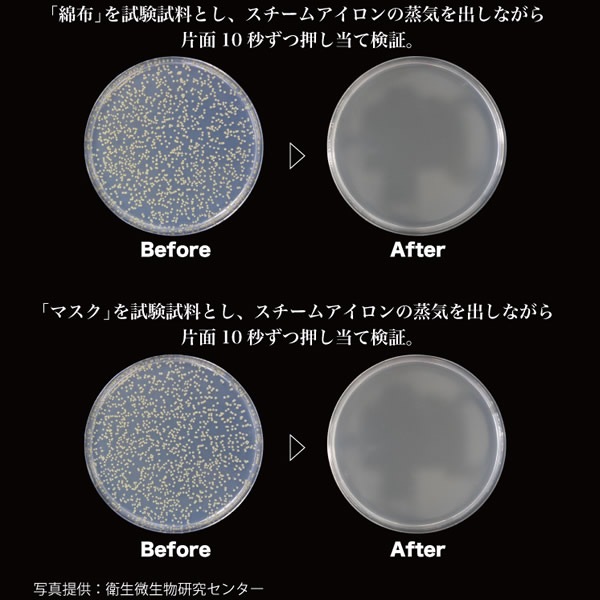

創業1964年 京都発家電卸の老舗 家電アドバイザーのいるお店

-
住宅設備


| 日 | 月 | 火 | 水 | 木 | 金 | 土 |
|---|---|---|---|---|---|---|
| 1 | 2 | 3 | 4 | |||
| 5 | 6 | 7 | 8 | 9 | 10 | 11 |
| 12 | 13 | 14 | 15 | 16 | 17 | 18 |
| 19 | 20 | 21 | 22 | 23 | 24 | 25 |
| 26 | 27 | 28 | 29 | 30 | 31 |
| 日 | 月 | 火 | 水 | 木 | 金 | 土 |
|---|---|---|---|---|---|---|
| 1 | ||||||
| 2 | 3 | 4 | 5 | 6 | 7 | 8 |
| 9 | 10 | 11 | 12 | 13 | 14 | 15 |
| 16 | 17 | 18 | 19 | 20 | 21 | 22 |
| 23 | 24 | 25 | 26 | 27 | 28 | 29 |
| 30 |

| 定格電圧・周波数 | 100V 50-60Hz |
|---|---|
| 定格消費電力 | 1000W |
| アイロンプレート温度 | 約110~120℃ |
| アイロンプレート加工 | フッ素コーティング |
| 本体重量 | 約750g |
| 本体サイズ | 約152×76×242mm |
| コード長 | 1.9m |
| 付属品 | スタンド、注水カップ、ブラシアタッチメント |